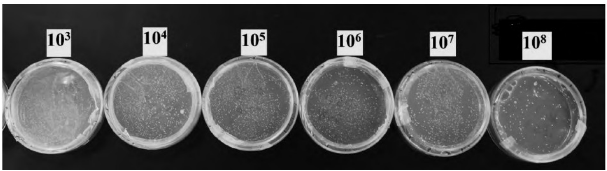
乳酸菌1.png

隨著人們對(duì)食品營(yíng)養(yǎng)和功能性的需求越來(lái)越大,飲食習(xí)慣逐漸轉(zhuǎn)向符合人們需求的食品——發(fā)酵食品。發(fā)酵食品主要包括由益生菌如乳桿菌屬�����、雙歧桿菌屬和革蘭氏陽(yáng)性球菌等所發(fā)酵而成的食品�。大量研究表明,乳酸菌不僅能改善食品的風(fēng)味�����,還具有調(diào)節(jié)機(jī)體胃腸道正常菌群��、保持微生態(tài)平衡�、降低血清膽固醇等保健功能,被廣泛應(yīng)用于輕工業(yè)�����、乳制品、醫(yī)藥及飼料等行業(yè)中�����。
活性乳酸菌飲料作為一種含活乳酸菌的發(fā)酵乳飲料�,因其可被益生菌當(dāng)作優(yōu)良載體,受到了消費(fèi)者的喜愛(ài)����。同時(shí),如何保證乳酸菌飲料中活菌數(shù)含量成為相關(guān)人員的重點(diǎn)研究方向�����。研究表明���,酸奶在貨架期內(nèi)���,p H值下降,酸度上升�,乳酸菌活菌數(shù)呈下降趨勢(shì),酸奶的整體感官評(píng)價(jià)下降�。研究發(fā)現(xiàn)在4℃條件下貯藏時(shí)�,乳酸菌生長(zhǎng)情況以及酸乳品質(zhì)最佳�,可有效延長(zhǎng)酸乳貨架期。本文從食品安全角度出發(fā)�����,以市售的4種活性乳酸菌飲料為研究對(duì)象��,測(cè)定其中的乳酸菌活菌數(shù)量�����,判斷其在保質(zhì)期內(nèi)是否符合宣傳內(nèi)容��,是否達(dá)到國(guó)家乳制品食品衛(wèi)生安全標(biāo)準(zhǔn)����。此外�,通過(guò)比較冷藏溫度和室溫保存溫度對(duì)乳酸菌活菌數(shù)的影響,評(píng)價(jià)不同品牌活性乳酸菌飲料的貯藏性差異以及為該類(lèi)產(chǎn)品的貯藏及消費(fèi)提供建議���。
1 材料與方法
1.1 材料�����、試劑與儀器
乳酸菌飲料A��、B�、C和D,市售�。
蛋白胨、牛肉膏����、酵母菌粉、醋酸鈉(乙酸鈉)���、磷酸氫二鉀��、檸檬酸銨����、硫酸鎂����、硫酸錳、瓊脂��、吐溫-80和葡萄糖����。
潔凈工作臺(tái)�����、高壓蒸汽滅菌鍋���、恒溫水浴培養(yǎng)箱、冰箱�����、數(shù)顯p H計(jì)����、天平����、移液槍、平板���、1.5m L EP管��、無(wú)菌水��、封口膜�����、250 m L錐形瓶���、1 L燒杯�����、玻璃棒����、1 L量筒��。
1.2 實(shí)驗(yàn)方法
1.2.1 培養(yǎng)基配制
本實(shí)驗(yàn)主要采用乳酸菌專(zhuān)用培養(yǎng)基MRS����,成分為蛋白胨10 g、牛肉膏10 g����、酵母菌粉5 g、醋酸鈉(乙酸鈉)5 g����、磷酸氫二鉀2 g����、檸檬酸銨2 g�、硫酸鎂0.2 g、硫酸錳0.2 g�、瓊脂20 g、吐溫-80 1 m L����、葡萄糖20 g,加水定容至1 000 m L后��,用冰乙酸調(diào)p H值至6.2~6.6���。因葡萄糖與蛋白胨發(fā)生反應(yīng),應(yīng)先將葡萄糖配制成母液���,分別滅菌后再按照比例加入�。
1.2.2 實(shí)驗(yàn)操作方法
實(shí)驗(yàn)分別取不同品牌的活性乳酸菌飲料1 m L進(jìn)行梯度稀釋?zhuān)♂尡稊?shù)為100~108���,每個(gè)稀釋梯度做3個(gè)平行��,并將每個(gè)稀釋梯度的3個(gè)平行樣涂布于已滅菌的MRS固體培養(yǎng)皿上�����,在4℃恒溫培養(yǎng)箱中培養(yǎng)��,每24 h觀察一次菌落生長(zhǎng)情況���。
1.2.3 保藏溫度為4℃時(shí)���,不同品牌MRS培養(yǎng)基中乳酸菌數(shù)目的測(cè)定
(1)乳酸菌的梯度稀釋。在無(wú)菌操作臺(tái)內(nèi)�,移液槍吸取1 m L樣品于1.5 m L離心管中,此管為原液管��。取8個(gè)1.5 m L離心管分別加入900μL無(wú)菌水�,依次編號(hào)1、2�、3、4�����、5、6��、7����、8號(hào)管。從原液管中吸取100μL液體于1號(hào)管����,再?gòu)?/span>1號(hào)吸取100μL液體置于2號(hào)管,依次重復(fù)操作至8號(hào)管���,最終稀釋為101~108倍��。
(2)涂布����。在無(wú)菌操作臺(tái)內(nèi)灼燒涂布棒��,并冷卻至室溫���。取一品牌不同梯度稀釋菌液樣品各100μL,均勻涂布在已滅菌的MRS固體培養(yǎng)基后并編號(hào)���。設(shè)置平行對(duì)照組��,其余3個(gè)品牌操作相同����。
(3)培養(yǎng)。將涂布完的培養(yǎng)基封口后倒置在恒溫培養(yǎng)箱內(nèi)��,4℃培養(yǎng)72 h后分別計(jì)數(shù)�����。
1.2.4 保藏溫度為20℃時(shí)�����,不同品牌MRS培養(yǎng)基中乳酸菌數(shù)目的測(cè)定
另購(gòu)買(mǎi)的活性乳酸菌飲料放置在20℃培養(yǎng)箱中72 h�����,模擬室溫保存乳酸菌飲料�。
(1)乳酸菌的梯度稀釋。在無(wú)菌操作臺(tái)內(nèi)����,移液槍吸取1 m L樣品于1.5 m L離心管中,此管為原液管。取8個(gè)1.5 m L離心管分別加入900μL無(wú)菌水���,依次編號(hào)1��、2�、3��、4��、5�����、6��、7��、8號(hào)管��。從原液管中吸取100μL液體于1號(hào)管���,再?gòu)?/span>1號(hào)吸取100μL液體置于2號(hào)管����,依次重復(fù)操作至8號(hào)管,最終稀釋為101~108倍��。
(2)涂布�����。在無(wú)菌操作臺(tái)內(nèi)灼燒涂布棒�����,并冷卻至室溫���。取一品牌不同梯度稀釋菌液樣品各100μL,均勻涂布在已滅菌的MRS固體培養(yǎng)基后并編號(hào)�。設(shè)置平行對(duì)照組,其余3個(gè)品牌操作相同�。
(3)培養(yǎng)。將涂布完的培養(yǎng)基封口后倒置在恒溫培養(yǎng)箱內(nèi)���,20℃培養(yǎng)72 h后分別計(jì)數(shù)�����。
1.2.5 數(shù)據(jù)分析
乳酸菌數(shù)目的計(jì)算方法是用肉眼觀察并計(jì)數(shù)����。實(shí)驗(yàn)數(shù)據(jù)均以平均值和標(biāo)準(zhǔn)方差表示,采用Origin2016數(shù)據(jù)統(tǒng)計(jì)軟件中的單因子方差分析(ANOVA)���。
2 結(jié)果與分析
2.1 不同梯度MRS培養(yǎng)基乳酸菌培養(yǎng)情況
由圖1可知��,乳酸菌菌落整體呈圓形�,微白色�����,凸起����,直徑為(3±1) mm,濕潤(rùn)�����,邊緣整齊����。

圖1 乳酸菌菌落形態(tài)
2.2 不同品牌乳酸菌活菌數(shù)檢測(cè)結(jié)果
由表1可知,A品牌乳酸菌活菌實(shí)際測(cè)量數(shù)為16.2億個(gè)/m L,B品牌乳酸菌活菌實(shí)際測(cè)量數(shù)為29.85億個(gè)/m L,C品牌實(shí)際測(cè)量數(shù)為26.15億個(gè)/m L,D品牌實(shí)際測(cè)量數(shù)為1.335億個(gè)/m L���。實(shí)驗(yàn)所用的4種市售活性乳酸菌飲料廣告宣傳活菌數(shù)均達(dá)到實(shí)際測(cè)量數(shù)����,符合其宣傳菌數(shù)要求,且實(shí)際測(cè)量數(shù)較廣告宣傳數(shù)大很多��。分析其原因?yàn)閺S家為保證廣告乳酸菌數(shù)目在保質(zhì)期內(nèi)成立���,廠家會(huì)在產(chǎn)品出廠時(shí)往產(chǎn)品中添加較多乳酸菌;廠家將廣告宣傳活菌數(shù)目降低��,以達(dá)到通過(guò)檢測(cè)的目的�����。

表1 4種乳酸菌飲料廣告宣傳度和實(shí)驗(yàn)室實(shí)際測(cè)量數(shù)的對(duì)比結(jié)果
2.3 不同保藏溫度對(duì)乳酸菌活菌數(shù)的影響
由圖2可知���,在保藏溫度為4℃時(shí)�����,4種品牌飲料中B品牌乳酸菌活菌數(shù)最多�����,且遠(yuǎn)大于D品牌(P<0.05)�,與其他品牌之間差異無(wú)統(tǒng)計(jì)學(xué)意義(P>0.05)。在保藏溫度為20℃時(shí)���,4種品牌乳飲料的乳酸菌活菌數(shù)均為0��,無(wú)顯著性差異(P>0.05)��。此外�,相同品牌在不同保藏溫度下的活菌數(shù)結(jié)果也略有不同��。A�、B、C品牌的乳酸菌飲料在4℃保藏時(shí)���,乳酸菌活菌數(shù)大于在20℃的培養(yǎng)結(jié)果(P<0.05)����,但D品牌在4℃保藏時(shí)的乳酸菌含量與20℃保藏并無(wú)太大差異(P>0.05)�。

圖2 不同保藏溫度對(duì)4種品牌的乳酸菌活菌數(shù)的影響
由以上結(jié)果可知,在保藏溫度為4℃時(shí)���,D品牌的乳酸菌數(shù)量雖然達(dá)到廣告符合標(biāo)準(zhǔn)��,但在所有品牌中乳酸菌活菌數(shù)最少����,其他各品牌間乳酸菌活菌數(shù)從多到少分別是B、C�、A。此外����,20℃對(duì)于乳飲料中乳酸菌活菌數(shù)的影響很大�����,幾乎沒(méi)有活菌檢出�����,建議消費(fèi)者購(gòu)買(mǎi)低溫保藏產(chǎn)品�,并在未飲用之前放置于低溫冷藏。
3 結(jié)論與討論
3.1 結(jié)論
本實(shí)驗(yàn)通過(guò)不同品牌活性乳酸菌飲料菌數(shù)符合度鑒定及不同溫度對(duì)活菌數(shù)的影響�,得出以下結(jié)論。(1) A���、B����、C和D品牌的活性乳酸菌飲料菌數(shù)達(dá)到均其宣傳數(shù),測(cè)量菌數(shù)分別為1.62×109個(gè)/m L���、2.985×109個(gè)/m L�����、2.615×109個(gè)/m L和1.335×108個(gè)/m L�。(2) 4種品牌乳飲料中B品牌乳酸菌含量最高���,與D品牌之間存在顯著性差異(P<0.05)�,與其他品牌之間差異無(wú)統(tǒng)計(jì)學(xué)意義(P>0.05)�����。(3)在保藏溫度為20℃時(shí)�����,4種品牌乳飲料的乳酸菌含量均為0�,無(wú)顯著性差異(P>0.05)。(4)活性乳酸菌飲料應(yīng)當(dāng)放置在4℃左右條件下貯藏,室溫會(huì)影響其乳酸菌活性和含量��。
3.2 討論
實(shí)驗(yàn)選取的4種市售活性乳酸菌飲料菌數(shù)均達(dá)到其宣傳數(shù)��。對(duì)市場(chǎng)乳酸菌飲料的抽檢結(jié)果表明��,兩種乳酸菌飲料在冷藏溫度下�����,乳酸菌數(shù)顯著下降��,但仍在其宣傳范圍內(nèi)�。本實(shí)驗(yàn)結(jié)果與結(jié)論相對(duì)比發(fā)現(xiàn),乳制品市場(chǎng)已經(jīng)趨于規(guī)范����,并未存在虛假宣傳的現(xiàn)象���。
此外�,本實(shí)驗(yàn)比較了溫度對(duì)乳酸菌數(shù)的影響�。當(dāng)不同品牌在溫度為4℃保藏時(shí),A����、B��、C培養(yǎng)結(jié)果之間差異無(wú)統(tǒng)計(jì)學(xué)意義����,且檢測(cè)出的活菌數(shù)量未低于廣告宣傳數(shù)�����。當(dāng)不同品牌在20℃下保藏時(shí)����,所有樣品中乳酸菌均未檢出,說(shuō)明20℃對(duì)于乳飲料中乳酸菌含量影響很大��,實(shí)驗(yàn)關(guān)于酸乳在4℃條件下貯藏時(shí)�,乳酸菌生長(zhǎng)情況以及酸乳品質(zhì)最佳,可有效延長(zhǎng)酸乳貨架期的結(jié)果相同��。在4℃保藏時(shí)�,A、B��、C品牌的乳酸菌含量大于20℃的活菌數(shù)(P<0.05)�����,但D品牌4℃保藏時(shí)乳酸菌含量與20℃保藏并無(wú)太大差異(P>0.05)。綜上所述����,所有活性乳酸菌飲料均應(yīng)當(dāng)放置在4℃條件下貯藏,20℃(室溫)會(huì)影響其乳酸菌活性和含量���,從而導(dǎo)致活性乳酸菌飲料的營(yíng)養(yǎng)價(jià)值降低��。建議消費(fèi)者購(gòu)買(mǎi)時(shí)�,挑選在保質(zhì)期內(nèi)的低溫保藏產(chǎn)品����,并在未飲用前放置于低溫冷藏。